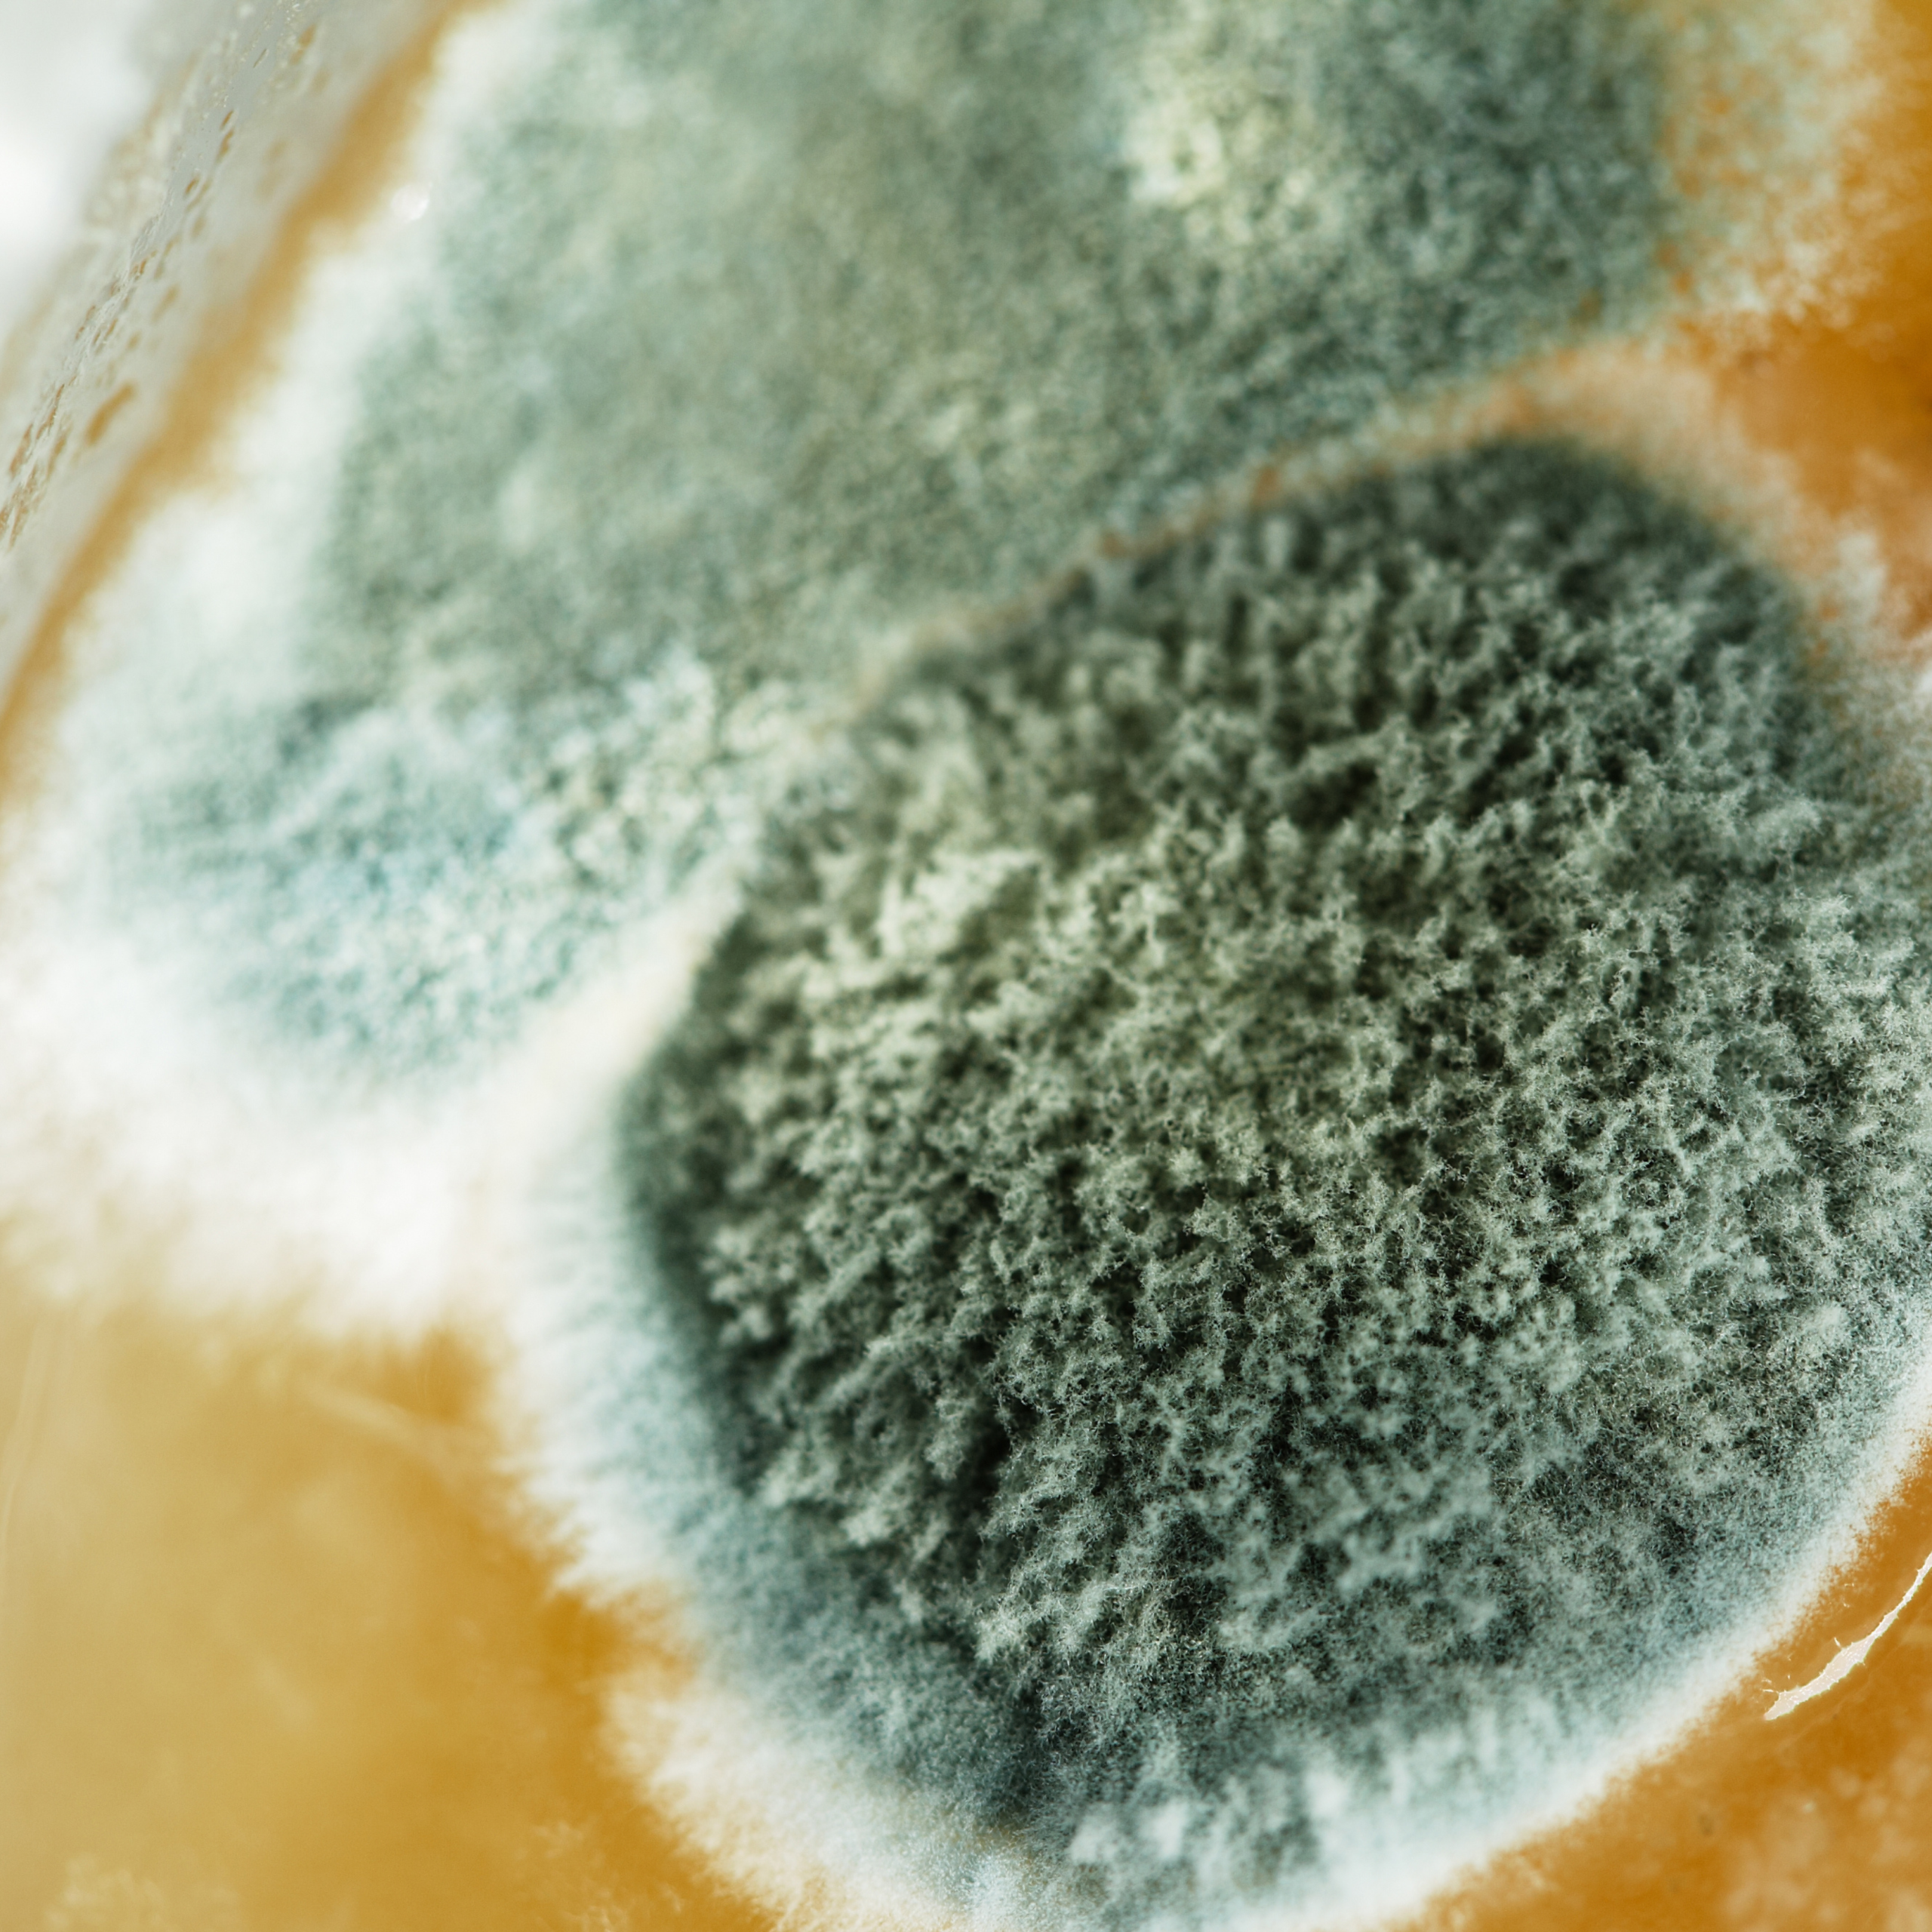

MOLD ABATEMENT
Mold growth poses risks to your property and health, often caused by hidden moisture. If untreated, it can damage structures, cause odors, and trigger respiratory issues. Prompt removal is essential.
Superior Water Restoration offers expert mold abatement across Utah, available 24/7 for emergency response. Our certified team locates moisture sources, contains affected areas, removes mold, and treats surfaces to prevent return.
Using advanced equipment and methods, we restore healthy conditions with minimal disruption. Contact us for professional mold inspection, removal, and restoration.
Available 24/7
Immediate Emergency Response
Honest & Transparent Pricing
100% Licensed & Insured Team
4.8 Stars on Google
Locally Owned & Operated
CONTAINMENT OF AFFECTED AREAS
The contaminated areas are sealed off using plastic barriers and negative air pressure to prevent mold spores from spreading.

MOISTURE CONTROL AND PREVENTION
We address the underlying moisture problems with drying equipment and repairs to prevent mold from returning.

MOLD REMOVAL AND CLEANING
Mold is removed using specialized cleaning agents and HEPA filtration. Severely damaged materials may be safely discarded.

RESTORATION AND FINAL DOCUMENTATION
Damaged materials are repaired or replaced to restore the property. Final testing ensures mold removal success and supports insurance claims.
SUPPORT WITH YOUR INSURANCE CLAIM
If you’ve ever felt lost in the insurance process, you’re not alone. That’s why restoration companies like ours are here: we bridge the gap between damage and recovery, making the claims process as smooth as possible.
Inspection & Documentation
We assess the damage, take detailed photos, and prepare all the necessary documentation for your insurance claim.
Insurance Coordination
We work directly with your insurance company, submitting paperwork and communicating with adjusters to make sure your claim is processed smoothly.
Restoration & Final Approval
Once your claim is approved, we restore, clean, and repair your property—ensuring everything meets your satisfaction before we finish.
We are Available 24/7!
Trusted restoration experts providing water, fire, mold, and smoke damage repair to protect your home.